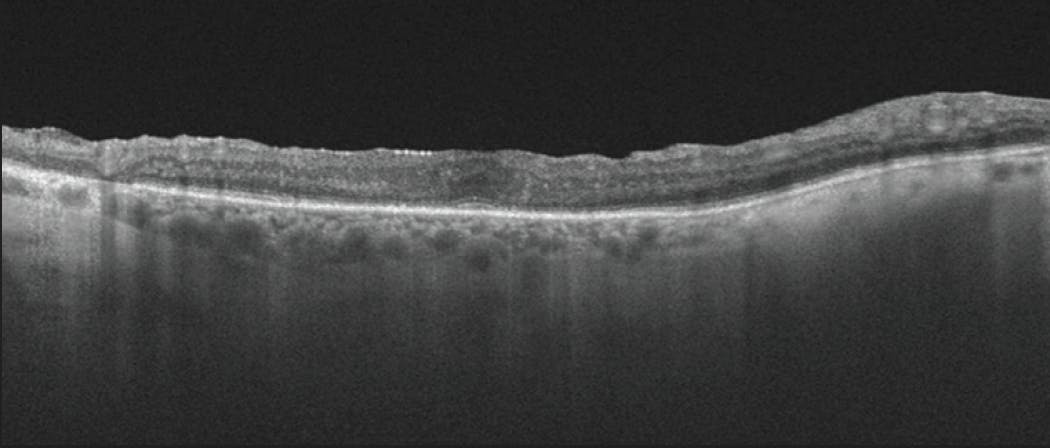
<p>Figure 3. A swept-source OCT volume scan showing the disorganization of retinal inner layers in a patient with diabetic macular edema.</p>
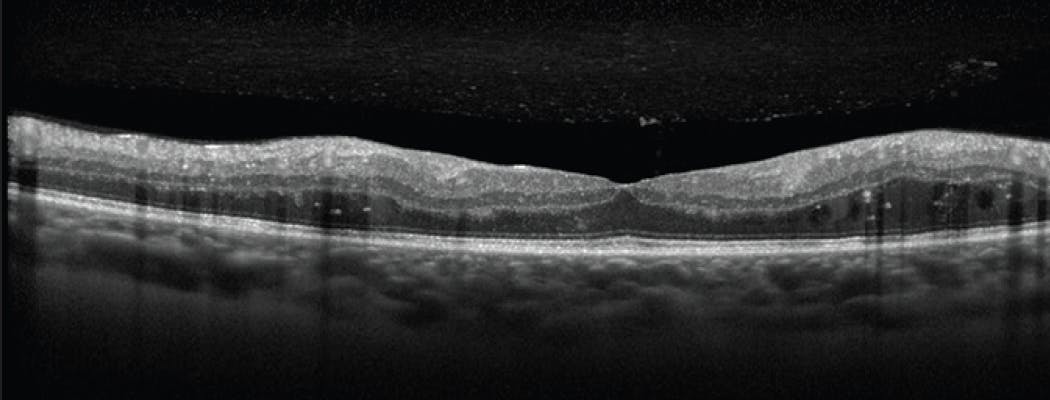

AT A GLANCE
- As newer OCT models increase the scanning speed and depth of penetration and decrease the signal-to-noise ratio, more of the retina will be visible on imaging.
- The relationships between clinical characteristics and imaging markers require advanced analytics such as artificial intelligence to uncover meaningful associations.
- Retinal fluid distribution, including intraretinal cystoid fluid, subretinal fluid, and subretinal pigmented epithelial fluid, have been investigated as imaging markers for wet AMD.
Researchers have long understood that the retina can be considered an extension of the brain, and its location allows for detailed anatomical and physiological analyses of neural mechanisms that underpin the brain’s primary information processing.1 Thus, it’s no surprise that retinal imaging, and OCT in particular, has grown so rapidly in the field of medicine as a means to diagnose, treat, and study diseases. Its application far exceeds that of ophthalmology, as ocular manifestations exist for a variety of systemic conditions, including hypertension, metastatic carcinoma, autoimmune conditions, acquired immunodeficiency syndrome, and diabetes.2
Unsurprisingly, as imaging of the retina has grown, so has our pattern recognition of retinal biomarkers. This is further aided by the use of artificial intelligence (AI), which has allowed identification of new biomarkers and the recharacterization of previous biomarkers to improve their utility when staging disease.
Several common OCT imaging biomarkers are being used in retinal vascular diseases (Table). Biofluid markers (eg, serum, plasma, aqueous, vitreous, and tears) for systemic conditions and anterior segment markers are not covered in this article, but will be shared in part 2 as they are also crucial in the understanding and treatment of disease.
WATCH THE FLUID & THE PERIPHERY
Separating fluid into its component parts has been an important marker for disease severity since the Comparison of Age-Related Macular Degeneration Treatments Trial, which showed that intraretinal cystoid spaces had a greater negative impact on visual acuity than subretinal fluid at all time points analyzed.3 Logically, fluid can cause disruption of any of the 10 retinal layers, hindering the processing of visual information.
As with most OCT-based biomarkers, retinal layer disruptions are now easier to discern with the increased resolution of retinal imaging. As newer OCT models increase the scanning speed and depth of penetration and decrease the signal-to-noise ratio, more of the retina will be visible on imaging, such as the choroid, which was inaccessible before the advent of enhanced depth imaging.
With the introduction of OCT angiography (OCTA), further vascular and choroidal neovascular membrane patterns have been discovered as biomarkers. Further segmentation of OCTA scans into the superficial capillary plexus and deep capillary plexus also adds further information, as clinicians can measure the density of vessels in these layers.
Aside from macular markers, additional biomarkers exist in the peripheral retina that are associated with various retinal vascular conditions, such as peripheral retinal ischemia in diabetic macular edema. Therefore, the field of view provided by an imaging device must be taken into account when assessing biomarkers.4
ADVANCED ANALYTICS
As retinal imaging modalities continue to increase in complexity, the relationships between clinical characteristics and imaging markers require advanced analytics such as AI to uncover meaningful associations. AI can now help to analyze OCT images, fundus photography, and other imaging modalities and has demonstrated an accurate diagnostic ability and structure-function mapping of the retina (Figure 1).5,6 In addition, using AI to analyze outer retinal thickness, hyperreflective foci, and area of drusen on OCT has demonstrated prognostic capabilities.7 For example, in patients with AMD and geographic atrophy (GA), a thinner outer nuclear layer was predictive of functional outcomes on microperimetry using an AI model.6 The progression of GA was further evaluated using deep learning analysis of OCT, where increased hyperreflective foci concentrations in the junctional zone were predictive of loss of retinal pigmented epithelium.8 Other studies have confirmed hyperreflective foci on OCT, along with drusen, as predictive of AMD progression.7,9

Figure 1. An example of the steps involved when using an AI algorithm to analyze OCT scans. Each swept-source OCT volume scan can first be automatically segmented into retinal layers (A). This results in retinal layers (B) that can be used as an additional information source to encode spatial information regarding the location of fluid within the retina (C).
Although similar biomarkers are analyzed on fundus photographs using AI with the intention of diagnosing patients with AMD, many of these studies do not report imaging findings but rather the algorithm’s diagnosis accuracy.10
AI AND THE FUTURE
Imaging markers for wet AMD are distinct from those for GA, with OCT being the most commonly investigated imaging modality.11 Retinal fluid distribution, including intraretinal cystoid fluid, subretinal fluid, and subretinal pigmented epithelial fluid have been investigated as imaging markers for wet AMD.12-14 Image-segmenting AI could help quantify these fluids, providing a more accurate evaluation of their clinical effect and relationship to visual morbidity.
Figure 3. A swept-source OCT volume scan showing the disorganization of retinal inner layers in a patient with diabetic macular edema.
Some of the structural markers common in GA also have been associated with wet AMD development, including compromised photoreceptor layer integrity; hyperreflective bands and foci on OCT; retinal pigment epithelium tears; and choroidal features.11 OCT is particularly conducive to AI analysis given it’s structured and segmented presentation, and the biomarkers identified above could plausibly be investigated using AI. Thus, AI algorithms could be implemented in clinical contexts to improve diagnostics and support clinical decision making for retina specialists treating patients with wet AMD and other conditions.15
1. Dowling JE. The Retina: An Approachable Part of the Brain. Cambridge, Massachusetts and London, England: Harvard University Press; 1987.
2. Tang RA. Ocular manifestations of systemic disease. American Academy of Ophthalmology; 1996.
3. Jaffe GJ, Martin DF, Toth CA, et al. Macular morphology and visual acuity in the comparison of age-related macular degeneration treatments trials. Ophthalmology. 2013;120(9):1860-1870.
4. Sodhi SK, Golding J, Trimboli C, Choudhry N. Feasibility of peripheral OCT imaging using a novel integrated SLO ultra-widefield imaging swept-source OCT device. Int Ophthalmol. 2021;41(8):2805-2815.
5. Corazza P, Maddison J, Bonetti P, et al. Predicting wet age-related macular degeneration (AMD) using DARC (detecting apoptosing retinal cells) AI (artificial intelligence) technology. Expert Rev Mol Diagn. 2020;21(1):109-118.
6. Pfau M, Emde L von der, Dysli C, et al. Determinants of cone and rod functions in geographic atrophy: AI-based structure-function correlation. Am J Ophthalmol. 2020;217:162-173.
7. Schmidt-Erfurth U, Waldstein SM, et al. Prediction of individual disease conversion in early AMD using artificial intelligence. Invest Opthalmol Vis Sci. 2018;59(8):3199.
8. Schmidt-Erfurth U, Bogunovic H, Grechenig C, et al. Role of deep learning–quantified hyperreflective foci for the prediction of geographic atrophy progression. Am J Ophthalmol. 2020;216:257-270.
9. Waldstein SM, Vogl W-D, Bogunovic H, Sadeghipour A, Riedl S, Schmidt-Erfurth U. Characterization of drusen and hyperreflective foci as biomarkers for disease progression in age-related macular degeneration using artificial intelligence in optical coherence tomography. JAMA Ophthalmol. 2020;138(7):740-747.
10. Dong L, Yang Q, Zhang RH, Wei WB. Artificial intelligence for the detection of age-related macular degeneration in color fundus photographs: A systematic review and meta-analysis. Eclinicalmedicine. 2021;35:100875.
11. Metrangolo C, Donati S, Mazzola M, et al. OCT biomarkers in neovascular age-related macular degeneration: a narrative review. J Ophthalmol. 2021;2021:9994098.
12. Lai T-T, Hsieh Y-T, Yang C-M, Ho T-C, Yang C-H. Biomarkers of optical coherence tomography in evaluating the treatment outcomes of neovascular age-related macular degeneration: a real-world study. Sci Rep-uk. 2019;9(1):529.
13. Sadda SR, Tuomi LL, Ding B, Fung AE, Hopkins JJ. Macular atrophy in the HARBOR study for neovascular age-related macular degeneration. Ophthalmology. 2018;125(6):878-886.
14. Schmidt-Erfurth U, Waldstein SM, Deak G-G, Kundi M, Simader C. Pigment epithelial detachment followed by retinal cystoid degeneration leads to vision loss in treatment of neovascular age-related macular degeneration. Ophthalmology. 2015;122(4):822-832.
15. Kapoor R, Whigham BT, Al-Aswad LA. Artificial intelligence and optical coherence tomography imaging. Asia-pacific J Ophthalmol. 2019;8(2):187-194.